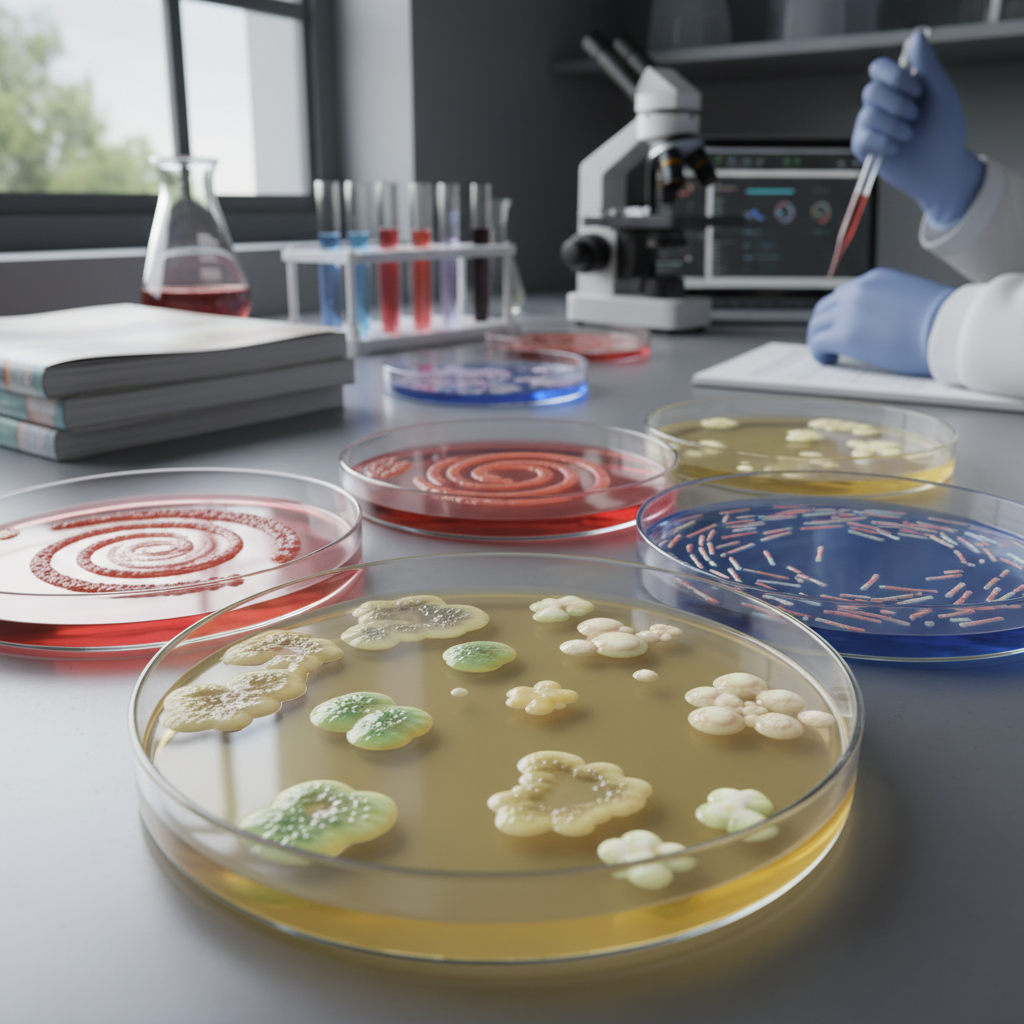

15 Autoimmune Condition Triggers Being Studied by Researchers Right Now
Autoimmune diseases affect millions of people worldwide, representing a complex category of conditions where the body's immune system mistakenly attacks its own healthy tissues. While genetic predisposition plays a crucial role in autoimmune disease development, researchers are increasingly recognizing that environmental triggers often serve as the catalyst that transforms genetic susceptibility into active disease. The intricate interplay between genetics, environmental factors, and immune system dysfunction has become a focal point of cutting-edge research, as scientists work to unravel the mysterious mechanisms that initiate and perpetuate autoimmune responses. Current investigations are revealing fascinating connections between seemingly unrelated factors—from viral infections and dietary components to stress hormones and environmental toxins—all of which may contribute to the development of conditions such as rheumatoid arthritis, multiple sclerosis, type 1 diabetes, and inflammatory bowel disease. Understanding these triggers is not merely an academic exercise; it represents a critical pathway toward developing more effective prevention strategies, earlier diagnostic tools, and targeted therapeutic interventions that could dramatically improve outcomes for the estimated 50 million Americans living with autoimmune conditions.
1. Viral Infections as Molecular Mimicry Catalysts

Viral infections have emerged as one of the most compelling autoimmune triggers under intensive research scrutiny, with scientists discovering that certain viruses can initiate autoimmune responses through a phenomenon known as molecular mimicry. This process occurs when viral proteins share structural similarities with human proteins, causing the immune system to mistakenly target the body's own tissues after successfully mounting a defense against the invading virus. Epstein-Barr virus (EBV), which causes mononucleosis, has been particularly implicated in multiple sclerosis development, with recent studies showing that nearly 100% of MS patients have evidence of prior EBV infection compared to 94% of healthy controls. Researchers at Harvard Medical School published groundbreaking findings in 2022 demonstrating that EBV infection increases the risk of developing MS by 32-fold, suggesting a causal relationship rather than mere correlation. Similarly, cytomegalovirus (CMV) has been linked to rheumatoid arthritis development, while Coxsackievirus B has shown strong associations with type 1 diabetes onset in genetically susceptible individuals. The timing of viral exposure appears crucial, with childhood infections potentially having more profound long-term autoimmune consequences than adult exposures, leading researchers to investigate whether targeted antiviral therapies or vaccination strategies could prevent autoimmune disease development in high-risk populations.
2. Gut Microbiome Dysbiosis and Immune System Education

The human gut microbiome, consisting of trillions of microorganisms that inhabit our digestive tract, has revolutionized our understanding of autoimmune disease triggers, with researchers discovering that disruptions in microbial diversity and composition can profoundly influence immune system development and function. The concept of dysbiosis—an imbalance in the gut microbiome characterized by reduced beneficial bacteria and increased pathogenic species—has been consistently observed in patients with various autoimmune conditions, including inflammatory bowel disease, rheumatoid arthritis, and multiple sclerosis. Recent research has revealed that the gut microbiome plays a crucial role in training the immune system during early life, helping to establish tolerance to self-antigens and preventing autoimmune responses. When this delicate ecosystem is disrupted by factors such as antibiotic use, dietary changes, or infections, the resulting dysbiosis can lead to increased intestinal permeability (leaky gut syndrome) and chronic inflammation that may trigger autoimmune responses in genetically susceptible individuals. Particularly intriguing is the discovery of specific bacterial strains that appear to either protect against or promote autoimmune disease development; for instance, certain Lactobacillus species have shown protective effects against type 1 diabetes, while Prevotella copri has been associated with increased rheumatoid arthritis risk. These findings have sparked intense research into microbiome-based therapeutic interventions, including targeted probiotics, fecal microbiota transplantation, and dietary modifications designed to restore healthy microbial balance.
3. Chronic Stress and Hypothalamic-Pituitary-Adrenal Axis Dysfunction

The relationship between chronic psychological stress and autoimmune disease development has become a major focus of research, with scientists uncovering sophisticated mechanisms through which prolonged stress exposure can dysregulate immune function and trigger autoimmune responses. The hypothalamic-pituitary-adrenal (HPA) axis, which governs the body's stress response system, normally helps maintain immune homeostasis through the release of cortisol and other stress hormones that have anti-inflammatory properties. However, chronic stress can lead to HPA axis dysfunction, characterized by either excessive cortisol production (which can suppress beneficial immune responses) or cortisol resistance (which allows unchecked inflammation to persist). Research has shown that individuals who experience significant life stressors, such as trauma, bereavement, or chronic work-related stress, have increased rates of autoimmune disease development, with some studies indicating that major stressful events can precede autoimmune disease onset by several months to years. The mechanisms underlying this relationship involve complex interactions between stress hormones, inflammatory cytokines, and immune cell function, with chronic stress promoting the production of pro-inflammatory molecules while simultaneously impairing regulatory T-cell function that normally prevents autoimmune responses. Additionally, stress-induced changes in sleep patterns, dietary habits, and social behaviors can further compound immune dysfunction, creating a cascade of physiological changes that increase autoimmune disease susceptibility in genetically predisposed individuals.
4. Environmental Toxins and Chemical Exposure Pathways

Environmental toxins and chemical exposures represent an increasingly recognized category of autoimmune triggers, with researchers identifying numerous synthetic compounds that can disrupt immune system function and promote autoimmune disease development through various mechanisms. Heavy metals such as mercury, lead, and cadmium have been extensively studied for their autoimmune-promoting properties, with exposure occurring through contaminated water sources, occupational settings, dental amalgams, and certain foods. These metals can bind to self-proteins and alter their structure, creating neo-antigens that the immune system recognizes as foreign, potentially triggering autoimmune responses against the modified proteins and, subsequently, against normal tissue components. Pesticides and herbicides, particularly organochlorines and organophosphates, have been linked to increased rates of rheumatoid arthritis and systemic lupus erythematosus, with agricultural workers showing higher autoimmune disease prevalence than the general population. Volatile organic compounds (VOCs) found in household products, building materials, and industrial emissions can also contribute to autoimmune disease development by promoting chronic inflammation and oxidative stress that damages cellular components and creates conditions conducive to autoimmune responses. Recent research has focused on endocrine-disrupting chemicals (EDCs) such as bisphenol A (BPA) and phthalates, which can interfere with hormone signaling pathways that normally help regulate immune function, potentially explaining the higher prevalence of autoimmune diseases in women and the increasing incidence of these conditions in developed countries with greater chemical exposure.
5. Dietary Triggers and Food Sensitivity Mechanisms

The role of dietary factors in autoimmune disease development has gained significant research attention, with scientists investigating how specific foods and dietary patterns can either trigger or protect against autoimmune responses through multiple biological pathways. Gluten, the protein found in wheat, barley, and rye, has been extensively studied not only for its role in celiac disease but also for its potential to trigger other autoimmune conditions through increased intestinal permeability and cross-reactive immune responses. Research has revealed that gluten consumption can increase zonulin production, a protein that regulates intestinal tight junctions, leading to increased gut permeability that allows partially digested food proteins and bacterial components to enter the bloodstream and potentially trigger immune responses. Additionally, molecular mimicry between gluten proteins and human tissue antigens may explain why some individuals with celiac disease also develop other autoimmune conditions such as type 1 diabetes or autoimmune thyroid disease. Ultra-processed foods, which are high in additives, preservatives, and artificial ingredients, have been associated with increased autoimmune disease risk through their effects on gut microbiome composition and inflammatory pathways. Conversely, anti-inflammatory dietary patterns such as the Mediterranean diet, which emphasizes omega-3 fatty acids, antioxidants, and fiber-rich foods, have shown protective effects against autoimmune disease development and progression. Researchers are particularly interested in understanding how food timing, preparation methods, and individual genetic variations in food metabolism contribute to autoimmune disease susceptibility, leading to investigations into personalized nutrition approaches for autoimmune disease prevention and management.
6. Sleep Disruption and Circadian Rhythm Dysregulation

Sleep disruption and circadian rhythm dysregulation have emerged as significant autoimmune disease triggers, with mounting research evidence demonstrating that irregular sleep patterns can profoundly impact immune system function and increase susceptibility to autoimmune responses. The circadian clock system, which governs 24-hour biological rhythms, plays a crucial role in regulating immune cell activity, cytokine production, and inflammatory responses throughout the day and night. When this system is disrupted by factors such as shift work, jet lag, artificial light exposure, or chronic insomnia, the resulting circadian misalignment can lead to immune dysfunction characterized by increased pro-inflammatory cytokine production and impaired regulatory T-cell function. Research has shown that individuals who work night shifts or experience chronic sleep deprivation have higher rates of autoimmune diseases, including rheumatoid arthritis, inflammatory bowel disease, and multiple sclerosis. The mechanisms underlying this relationship involve complex interactions between circadian clock genes, immune cell trafficking patterns, and hormone production cycles, with disrupted sleep leading to elevated cortisol levels, altered melatonin production, and dysregulated inflammatory responses. Additionally, sleep deprivation can compromise the blood-brain barrier and increase intestinal permeability, potentially allowing immune system access to normally protected tissues and triggering autoimmune responses. Recent studies have also revealed that the timing of immune challenges, such as infections or stress exposure, relative to circadian rhythms can significantly influence the likelihood of developing autoimmune responses, suggesting that circadian-based therapeutic interventions may offer new approaches for autoimmune disease prevention and treatment.
7. Hormonal Fluctuations and Endocrine System Imbalances

Hormonal fluctuations and endocrine system imbalances represent critical autoimmune disease triggers that help explain the striking gender disparities observed in autoimmune conditions, with women being disproportionately affected by most autoimmune diseases. Estrogen, the primary female sex hormone, has complex immunomodulatory effects that can both enhance and suppress immune responses depending on concentration levels, timing, and individual genetic factors. Research has shown that estrogen can promote the survival and activation of autoreactive B cells while also enhancing the production of autoantibodies, potentially explaining why many autoimmune diseases have peak onset during reproductive years when estrogen levels are highest. Pregnancy represents a unique hormonal environment that can dramatically influence autoimmune disease activity, with some conditions improving during pregnancy due to increased regulatory T-cell activity and anti-inflammatory cytokine production, while others may worsen or first appear during the postpartum period when hormone levels rapidly decline. Thyroid hormones also play crucial roles in immune system regulation, with both hyperthyroidism and hypothyroidism being associated with increased autoimmune disease risk through their effects on immune cell function and inflammatory pathways. Additionally, insulin resistance and metabolic dysfunction can create hormonal imbalances that promote chronic inflammation and autoimmune responses, with research showing strong associations between metabolic syndrome and autoimmune disease development. The discovery of hormone receptors on immune cells has revealed direct pathways through which endocrine disruption can influence autoimmune disease susceptibility, leading to investigations into hormone replacement therapy, selective estrogen receptor modulators, and other endocrine-targeted interventions for autoimmune disease prevention and treatment.
8. Smoking and Tobacco-Related Inflammatory Cascades

Smoking and tobacco use have been identified as major modifiable risk factors for autoimmune disease development, with extensive research demonstrating that tobacco exposure can trigger and exacerbate autoimmune responses through multiple inflammatory and immunomodulatory pathways. The relationship between smoking and rheumatoid arthritis has been particularly well-documented, with smokers having a two to three-fold increased risk of developing the disease compared to non-smokers, and smoking being associated with more severe disease progression and reduced treatment response. The mechanisms underlying this relationship involve the production of citrullinated proteins in the lungs of smokers, which can serve as targets for anti-citrullinated protein antibodies (ACPAs) that are characteristic of rheumatoid arthritis. Tobacco smoke contains over 4,000 chemicals, many of which can directly damage tissues and promote chronic inflammation, while also altering immune cell function and promoting the production of pro-inflammatory cytokines. Research has shown that smoking can increase intestinal permeability, disrupt the gut microbiome, and promote the translocation of bacterial components that can trigger systemic immune responses. Additionally, smoking has been linked to increased risk of multiple sclerosis, with studies suggesting that tobacco exposure may promote blood-brain barrier dysfunction and central nervous system inflammation. The timing and duration of smoking exposure appear to be critical factors, with early-life exposure potentially having more profound long-term autoimmune consequences than adult-onset smoking. Importantly, smoking cessation has been shown to reduce autoimmune disease risk and improve treatment outcomes, although some studies suggest that former smokers may retain elevated risk for several years after quitting, highlighting the importance of early prevention efforts.
9. Vitamin D Deficiency and Immune System Modulation

Vitamin D deficiency has emerged as a significant autoimmune disease trigger, with extensive research revealing that this hormone-like vitamin plays crucial roles in immune system regulation and that inadequate levels can promote autoimmune responses through multiple mechanisms. Vitamin D functions as an immunomodulator by binding to vitamin D receptors found on various immune cells, including T cells, B cells, and antigen-presenting cells, where it promotes the development of regulatory T cells while suppressing the differentiation of pro-inflammatory Th1 and Th17 cells. Epidemiological studies have consistently shown that individuals living at higher latitudes, where sun exposure and vitamin D synthesis are limited, have higher rates of autoimmune diseases such as multiple sclerosis, type 1 diabetes, and inflammatory bowel disease. The "latitude gradient" observed in multiple sclerosis prevalence, with rates increasing dramatically as distance from the equator increases, has been largely attributed to reduced vitamin D levels in populations with limited sun exposure. Research has demonstrated that vitamin D deficiency can impair the function of regulatory T cells, which are essential for maintaining immune tolerance and preventing autoimmune responses against self-antigens. Additionally, vitamin D influences the production of antimicrobial peptides that help maintain gut barrier function and microbial balance, with deficiency potentially contributing to increased intestinal permeability and dysbiosis that can trigger autoimmune responses. Recent clinical trials have investigated vitamin D supplementation as a therapeutic intervention for autoimmune diseases, with some studies showing modest benefits in disease activity and progression, although optimal dosing strategies and target populations remain areas of active investigation.
10. Molecular Mimicry from Bacterial Infections
Bacterial infections represent another significant category of autoimmune triggers, with researchers discovering that certain bacterial pathogens can initiate autoimmune responses through molecular mimicry mechanisms similar to those observed with viral infections. Streptococcus pyogenes, the bacterium responsible for strep throat, has been extensively studied for its role in triggering rheumatic fever and PANDAS (Pediatric Autoimmune Neuropsychiatric Disorders Associated with Streptococcal Infections) through cross-reactive immune responses between streptococcal proteins and human tissue antigens. The M protein found on the surface of group A streptococci shares structural similarities with cardiac myosin, leading to the production of antibodies that can attack both the bacterial pathogen and heart tissue, resulting in rheumatic heart disease. Similarly, Campylobacter jejuni infections have been strongly linked to Guillain-Barré syndrome development through molecular mimicry between bacterial lipopolysaccharides and gangliosides found in peripheral nerve tissue. Research has revealed that the timing and severity of bacterial infections can influence the likelihood of developing autoimmune complications, with more severe infections and those occurring during critical developmental periods potentially having greater autoimmune consequences. Additionally, chronic bacterial infections such as those caused by Helicobacter pylori have been associated with increased risk of autoimmune gastritis and other autoimmune conditions, possibly through sustained inflammatory responses and epitope spreading mechanisms. The discovery of these bacterial triggers has led to investigations into antibiotic prophylaxis strategies for high-risk individuals and the development of vaccines that could prevent both infectious disease and associated autoimmune complications.
11. Physical Trauma and Tissue Damage Responses

Physical trauma and tissue damage have been recognized as potential autoimmune disease triggers, with research revealing that mechanical injury, surgical procedures, and other forms of tissue damage can initiate autoimmune responses through the release of normally sequestered self-antigens and the activation of innate immune pathways. The concept of "epitope spreading" helps explain how localized tissue damage can evolve into systemic autoimmune disease, as initial immune responses against damage-associated molecular patterns (DAMPs) released from injured tissues can subsequently expand to target related but previously tolerated self-antigens. Studies have documented cases of autoimmune diseases developing following traumatic injuries, with some research suggesting that the severity and location of trauma may influence the type and likelihood of subsequent autoimmune responses. Surgical procedures, particularly those involving significant tissue manipulation or the implantation of foreign materials, have been associated with increased autoimmune disease risk in some individuals, possibly through the creation of neo-antigens formed by the combination of self-proteins with foreign substances. Additionally, repetitive microtrauma, such as that experienced by athletes or individuals in certain occupations, may contribute to chronic inflammatory states that can predispose to autoimmune disease development. The role of adjuvants—substances that enhance immune responses—in trauma-